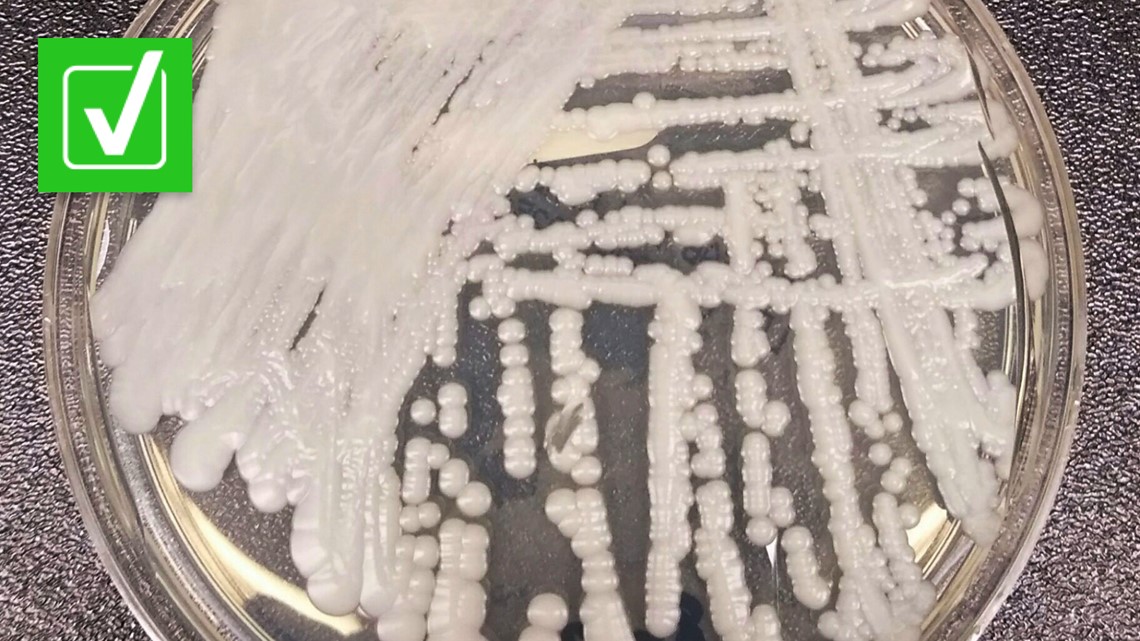
Featured image for The Spread of Drug-Resistant Fungus in U.S. Health Care Facilities.

California Faces a Drug-Resistant Fungus: Candida auris Spreads in Healthcare Settings
Candida auris, a deadly drug-resistant fungus, has infected more than 7,000 people across 27 states including California, with 1,524 California cases reported in 2025 and a few in 2026. It can cause skin, wound, urinary, and bloodstream infections and is difficult to treat, contributing to a roughly 34% mortality rate in 2016–2022. The infection spreads in healthcare settings via surfaces and equipment, and prevention focuses on strict hand hygiene, patient isolation, room disinfection, and PPE. Vulnerable patients with severe underlying illness are at highest risk; several states report ongoing outbreaks.